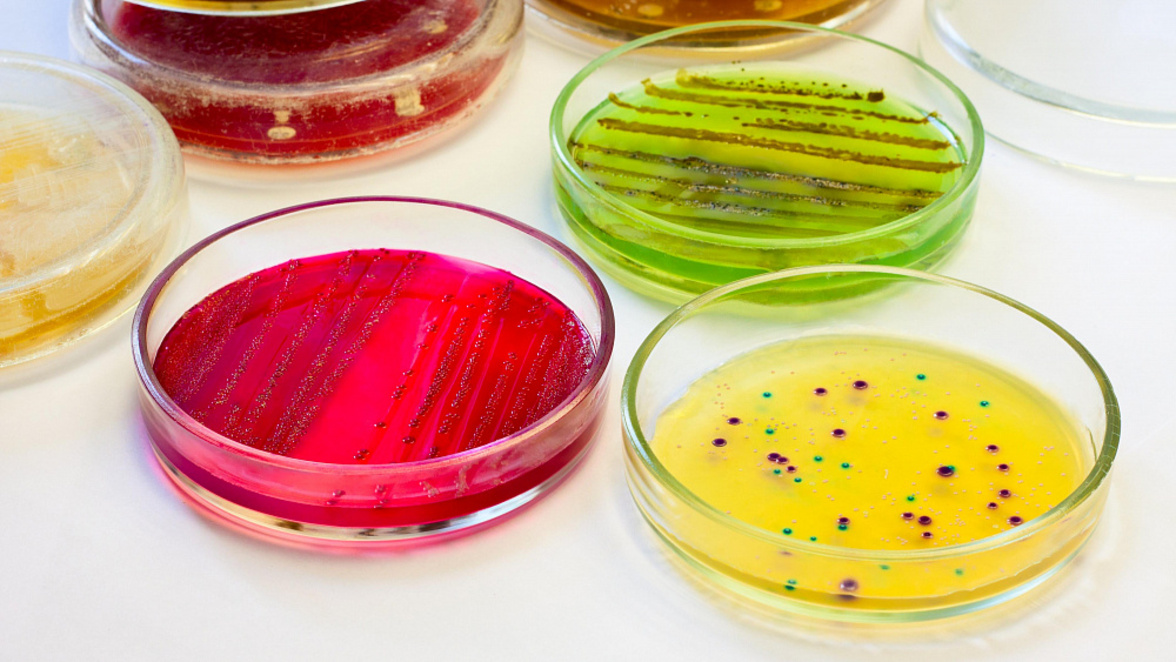
На разработку питательных сред выделят субсидии

Подведомственные Роспотребнадзору учреждения при проведении ими лабораторных исследований, предусмотренных госзаданием, получат субсидии на разработку питательных сред и тест-систем для диагностики инфекционных заболеваний. Соответствующий проект приказа размещен на портале проектов нормативных правовых актов.
Объем субсидии будет рассчитываться на основании представленного учреждением финансово-экономического обоснования заявленного размера субсидии. Результатом предоставления субсидии будет являться количество (объем) произведенных питательных сред и тест-систем для диагностики инфекционных заболеваний, соответствующих объему государственного задания на проведение лабораторных исследований.
Надзорный орган также опубликовал правила получения таких субсидий. Так, подведомственные учреждения Роспотребнадзора представляют в срок до 15 января очередного финансового года заявки на цели предоставления субсидии, с приложением плана-графика их распределения по учреждениям и с указанием информации об объемах.
Накануне Минпромторг предложил установить балльные критерии для оценки степени локализации готовых питательных сред для выращивания микроорганизмов. Соответствующий проект постановления размещен на портале проектов нормативных правовых актов. Изменения предлагается внести в приложение к постановлению правительства № 719 от 17.07.2015. Документ вступит в силу со дня его подписания.
В августе 2021 года Минпромторг предложил оценивать локализацию производства медицинских изделий в России по балльной системе, наращивая долю отечественных компонентов, которые используются для создания шприцев, катетеров, стентов и других изделий. В министерстве заявляли, что система поможет накоплению научно-технического и производственного потенциала России, будет развивать медицинскую промышленность и выпуск медизделий. Также она снизит зависимость внутреннего рынка от поставок из других стран. В декабре 2022 года правительство приняло балльную систему определения страны происхождения для 24 наименований медизделий.
На прошлой неделе правительство установило балльные критерии для оценки степени локализации 18 видов медицинского оборудования. В частности, в список попали компьютерные томографы, маммографы, аппаратно-программные комплексы для регистрации и обработки рентгеновских изображений, а также оборудование для ПЦР исследований.